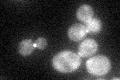
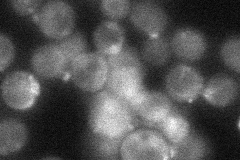
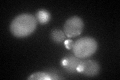

View description
GTPase-activating protein (RhoGAP) for Rho3p and Rho4p, possibly involved in control of actin cytoskeleton organization
Localization:
Intensity:
Fold change:
Significance:
-
C’ GFP library in SD
bud neck -
N' NOP1pr-GFP in SD

punctate,bud84.9006 -
N' TEF2pr-mCherry in SD

punctate,bud neck104.629 -
N' NATIVEpr-GFP in SD
bud neck33.5652 -
N' TEF2pr-VC and Cyto-VN in SD

#N/A0 -
C’ GFP library in SD+DTT
bud neck35.061.04No -
C’ GFP library in SD+H2O2

bud neck41.331.23No -
C’ GFP library in Starvation Media

punctateN/AN/AYes -
C’ GFP library on the background of Pup2-DaMP

bud neck -
C’ GFP library on the background of CCT mutant

bud neck36.06561.07987No
